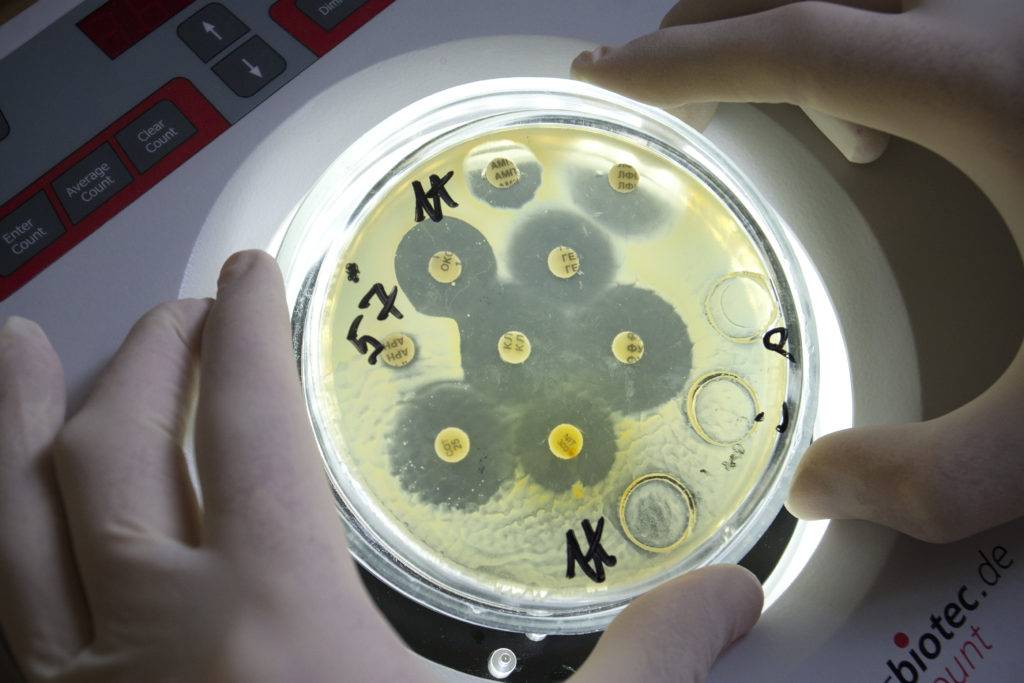

С целью диагностики ИППП у мужчин берут следующие анализы:
- Мазок из уретры, иногда из заднего прохода
- Сперму
- Секрет предстательной железы
- Мочу
- Кровь
- Эпителиальные соскобы
- Слюну
- Мокроту и др.
Урогенитальный мазок у мужчины берут с помощью специального стерильного зонда.

Мужчины в ходе этой процедуры испытывают определенную болезненность.
По этой причине в нашей клинике создан модифицированный, безболезненный способ взятия уретрального мазка.
Однако при нежелании сдавать мазок в некоторых случаях все же можно заменить его анализ исследованием осадка мочи.
Больно ли брать ПЦР мазок на ИППП у мужчин?
Мазок на ПЦР позволяет с точностью определить возбудителя
Мазок берет врач – уролог из уретрального канала.
Выполняется при помощи специального зонда, который вводят на глубину 4-5 сантиметров.
Процедура длиться пару минут.
Данная процедура является весьма неприятной, иногда болезненной.
Это нормально, так как происходит травмирование слизистых оболочек.
Как правило, болезненные ощущения спустя некоторое время проходят.
Уточните у своего врача, каким зондом проводится забор мазка.
Какими методами диагностируют ИППП у мужчин?
- 1.Бактериоскопия. Этот метод подразумевает микроскопическое исследование мазка с целью идентификации возбудителя инфекции – бактерий, грибков, простейших. Таким путем можно успешно диагностировать гонорею, кандидоз, трихомониаз. Метод эффективен в 40-50% случаев.
- 2.Бактериологический анализ. Подразумевает посев микроорганизмов на специальные питательные среды с целью их последующей идентификации. А также определения их чувствительности к антибактериальным препаратам. Такое исследование оказывается достоверным в 70-80% случаев за счет своей высокой чувствительности и специфичности.

- 3.Серологический анализ, или иммунодиагностика с помощью ИФА, РИФ, РСК, РНГА. Так в сыворотке крови пациента находят специфические антитела к возбудителю инфекции. Метод используют в диагностике сифилиса, хламидиоза, вирусных заболеваний.
- 4.ДНК-диагностика методом ПЦР. Подразумевает обнаружение в исследуемом материале (выделения из уретры, сперма, сок простаты, кровь, моча) генома возбудителя инфекции. Этот метод является самым точным (степень достоверности приближается к 100%) за счет высокой специфичности и чувствительности. Возможна одновременная диагностика на наличие сразу нескольких инфекций. Результаты исследования можно узнать в тот же день.

Лечение ИППП у мужчин осуществляется
Лечение ИППП у мужчин осуществляется согласно комплексным схемам.
Их индивидуально назначает врач-венеролог в каждом конкретном случае.
Во время медикаментозной терапии половых инфекций абсолютно запрещено употребление спиртного, курение и занятия сексом.

Схема лечения ИППП у мужчин
Даже при отсутствии симптоматики необходимо проводить лечение ИППП у мужчин.
Основным при лечении препаратом является антибиотик.
Назначаются антибиотики только врачом после полной диагностики.
Самыми эффективными антибиотиками при ИППП у мужчин являются:
- 1.Эритромицин
- 2.Азитромицин
- 3.Тетрациклин
- 4.Доксицилин
- 5.Офлоксацин
- 6.Неомицин
- 7.Спектиномицин
- 8.Цефтаролин
- 9.Метронидазол
Курс лечения проводят одну, две недели.
В тяжелых случаях длительность терапии составляет около 1 месяца.
Когда берут контрольные анализы после лечения ИППП у мужчин, результат подвердит эффективность проведенного лечения.
Осложнения ИППП у мужчин
В первую очередь стриктура уретры при ИППП у мужчин сужается.
Происходит распространение инфекции в другие органы и системы, приводя к хроническому воспалению.
Поражение яичек при ИППП у мужчин встречается довольно часто.
Воспаление яичек способствует нарушению сексуальной жизни мужчины и в будущем является причиной бесплодия.
Какой врач лечит ИППП у мужчин
При появлении первых признаков ИППП мы задаемся вопросом, к какому врачу обратиться?
Мужчине следует при появлении симптоматики половой инфекции посетить уролога или венеролога.
Специалист проведет тщательный осмотр.
На приеме у врача берется материал для диагностики.
По результатам лабораторных исследований назначается курс терапии.
Сдать анализы на ИППП, получить консультацию опытного врача-венеролога и пройти необходимое лечение вы сможете, обратившись в наш платный КВД.
При обнаружении любых симптомов ИППП, обращайтесь к автору этой статьи – венерологу, урологу в Москве с 15 летним опытом работы.
ПЦР-диагностика
Одним из лучших методов лабораторной диагностики ИППП является полимеразно-цепная реакция (ПЦР), позволяющая выявить наличие генетического материала любого возбудителя в организме человека.
Она эффективна во всех тех случаях, когда нужно обнаружить фрагмент ДНК, характерный только для конкретного микроорганизма. Неоспоримыми достоинствами ПЦР-диагностики инфекций являются:
- 1универсальность;
- 2высокая специфичность;
- 3большая чувствительность – с помощью ПЦР можно обнаружить даже минимальное количество генетического материала возбудителя;
- 4быстрота получения результата.
ПЦР широко используют и для выявления палочки Коха, вируса Эпштейн-Барра, ЦМВ, гепатитов A, B, C, D, G, Helicobacter pylori и других возбудителей.
В условиях лаборатории полученный биоматериал (кровь, слюна, моча и др.) помещают в специальную среду, в которой осуществляется наращивание фрагментов уже имеющихся ДНК.
5.1. ПЦР-12
Это комплексный анализ, позволяющий выявить 12 основных возбудителей половых инфекций:
- 1генитальный герпес (вирус герпеса 1,2),
- 2папилломавирусная инфекция (ВПЧ 16, 18),
- 3урогенитальный хламидиоз (Chlamydia trachomatis),
- 4цитомегаловирусную инфекцию,
- 5урогенитальный микоплазмоз (Mycoplasma hominis, Mycoplasma genitalium),
- 6уреаплазмоз (Ureaplasma spp.),
- 7гонорею (Neisseria gonorrhoeae),
- 8гарднереллез (Gardnerella vaginalis),
- 9трихомониаз (Trichomonas vaginalis),
- 10кандидоз (Candida albicans).
Для ПЦР-12 у мужчин берется соскоб из уретры через 2-3 часа после последнего мочеиспускания, а у женщин — мазок из заднего свода влагалища и цервикального канала. Этот анализ абсолютно безвреден, поэтому его можно сдавать и во время беременности.
Хорошие комплексы анализов предлагают коммерческие лаборатории (например, Инвитро, Гемотест, KDL). В такие комплексы обычно входит следующий перечень исследований:
- 1Анализ крови на ВИЧ и сифилис (определение антител методом ИФА, реже иммуноблот).
- 2Кровь на HbsAg и антитела к вирусу гепатита С (скрининг на гепатит В и С).
- 3Соскоб из уретры, заднего свода влагалища, цервикального канала. Часть полученного материала наносят на стекло, а другую часть — в пробирку для ПЦР.
- 4Методом ПЦР выявляют гарднереллы, кандиды, хламидии, микоплазмы (M. hominis, M. genitalium), уреаплазмы, гонококки, трихомонады, вирус простого герпеса и цитомегаловирус, а также ВПЧ (16 и 18 типа).
5.2. Расшифровка результатов
Положительный результат свидетельствует о том, что генетический материал конкретного возбудителя инфекции присутствует в организме. Такое возможно в следующих ситуациях:
- 1Возбудитель уже уничтожен организмом, заболевания нет, но его ДНК еще присутствует в материале, взятом для исследования (ложноположительный результат).
- 2Скрытая инфекция или носительство.
- 3Наличие конкретной ИППП в острой или хронической форме.
Отрицательный результат указывает на то, что в данном биологическом материале конкретный возбудитель не обнаружен. Наиболее типичные ситуации:
- Заболевания нет, человек здоров.
- Инфекция есть, но были погрешности в заборе материала, поэтому возбудитель не обнаружен (ложноотрицательный результат).
5.3. Экспресс-диагностика
Их неоспоримое преимущество – быстрый результат, который можно получить через 15-60 минут. Эти тесты можно выполнить в медицинском учреждении или дома после предварительной покупки в аптеке.
В настоящее время существуют экспресс-тесты для диагностики следующих заболеваний:
- 1ВИЧ-инфекции;
- 2гепатит В, С;
- 3генитальный герпес;
- 4сифилис;
- 5гонорея;
- 6хламидиоз.
Точный диагноз может поставить лишь врач, опираясь на жалобы пациента, историю заболевания, данные осмотра, а также результаты всех лабораторных и инструментальных исследований.
Перечень анализов на ЗППП для мужчин
При обследовании на ЗППП у мужчин, назначают следующие анализы:

Бактериоскопия. Для исследования из уретры проводят забор биологического материала. Уретра у мужчин достаточно узкая, поэтому процедура забора несколько сложнее. В мочеиспускательный канал мужчины врач вводит эластичную трубку на глубину два-три см. После забора материала пациент может некоторое время испытывать неприятные ощущения. Мазок распределяют по предметному стеклу и отправляют на исследование в лабораторию, где его помещают в благоприятную среду, в которой инфекция начнет интенсивно размножаться. Это позволит доктору подобрать эффективный лекарственный препарат. Результат можно будет узнать уже спустя пару дней, но в некоторых случаях может понадобиться более продолжительное время.
Анализ крови. Позволяет выявить напряженность иммунитета, повышение уровня лейкоцитов – лейкоцитоз со сдвигом лейкоцитарной формулы влево, что показательно для бактериальной инфекции. Так же анализ используют для постановки серологических реакций, с помощью которых выявляют либо антитела специфичных к возбудителю, либо антигены самого возбудителя.
ПЦР. Позволяет выявить возбудителя ЗППП. Является самым точным методом исследования. Для проведения анализа берут кровь, мазок или мочу. Метод позволяет точно определить наличие инфекции и исключить ложноположительные результаты. Даже при минимальном количестве молекул ДНК возбудителя можно диагностировать заболевание.
Спермограмма. Позволяет исключить или подтвердить поражение мужской репродуктивной системы, а также определить активность спермиев.
Иммуноферментный анализ. Позволяет выявить специфические антитела в ответ на определенное заболевание и подсчитать их количество. Метод позволяет выявить возбудителя и определить, когда произошло заражение и стадию заболевания.
Анализ мочи. Дает информацию о локализации инфекции, возбудителе и степени поражения мочеполовой системы мужчины. При наличии активного инфекционного процесса в моче определяется слизь.
Важно! ИФА и ПЦР наиболее достоверные и точные методики диагностики ЗППП
ИППП: соскоб и другие анализы
Для проверки на наличие ИППП необходимо обратиться к лечащему врачу. Он подскажет, к какому врачу обратиться. Обычно лечением женщин занимается гинеколог, а мужчин – уролог или андролог. А при отсутствии специалиста в поликлинике можно обратиться к венерологу.
После осмотра пациента врач возьмет соскоб на ИППП, а также даст направление и расскажет где можно сдать анализ крови.
Методы исследования на ИППП
Существует несколько методов анализа, позволяющих выявить наличие инфекционного заболевания:
Микроскопия – это исследование мазка под микроскопом, а также посев на питательные среды. Анализ проводится быстро, достаточно прост в исполнении. Позволяет обнаружить патогенную флору почти сразу после заражения. Какие инфекции обнаруживают при микроскопическом исследовании мазка?

Обычно это гонококки, гарднереллы и трихомонады.
Для исследования на ИППП берется соскоб со слизистых оболочек из влагалища – у женщин и из члена – у мужчин, а также изо рта и из заднего прохода. Тонкий слой выделений наносят на предметное стекло. После высушивания и окрашивания специальными красителями мазок изучают под микроскопом.
Среди недостатков метода следует отметить его низкую информативность.
Культуральный метод заключается в посеве выделений на питательные среды, на которых в течение нескольких суток наблюдается рост колоний микроорганзимов. По их внешним признакам удается провести идентификацию возбудителей. Также проводится определение чувствительности микроорганизмам к различным антибиотикам.
Достоверность методики приближается к (95%). К минусам можно отнести то, что не любая инфекция способна к росту в искусственных средах и анализ растянут во времени.
Иммуноферментный (ИФА) — метод исследования венозной крови. Широко используется для диагностики урогенитальных инфекционных заболеваний.
В основе исследования – проведение иммунных реакций: антиген плюс антитело. Метод позволяет выявить наличие антител (Ig) к той или иной инфекции. Они нейтрализуют действие микроорганизмов. Методика дает достоверные сведения о заражении организма, давности заболевания и позволяет определить стадию болезни.
ПЦР (полимеразная цепная реакция) является самым высокоточным (до 95%) методом исследования на ИППП. В его основе – определение ДНК организма в исследуемом биоматериале (крови, моче, соскобе выделений). ПЦР-диагностика позволяет выявлять даже инфекцию с высокой антигенной изменчивостью.
Плюсами данной методики являются возможность исследования любого биоматериала и быстрота анализа. Это дает возможность, как можно быстрее назначить больному лечение.
Как подготовиться
Что такое ИППП – краткий ответ на этот вопрос, а также информация об их опасности и распространенности, даны в первом блоке. Поскольку риск заражения такими инфекциями в современном обществе достаточно высок, анализ, способный выявить наличие заболеваний, передающихся половым путём, относится к числу обязательных при прохождении медицинских комиссий, в том числе на профпригодность.
Что необходимо сделать пациенту прежде, чем сдать анализы на половые инфекции, как сдавать эти анализы, и как правильно подготовиться к исследованию, чтобы результат был максимально точным?
При малейшем подозрении на заражение болезнью, передающейся во время сексуального контакта, необходимо обратиться к врачу. Конечно, подозрение не значит стопроцентного наличия диагноза, но провериться все же необходимо.
Доктор проведет осмотр и назначит нужные экспертизы. Подготовка перед сдачей анализов на ИППП зависит от того, какой биоматериал пациент сдаёт на исследование.
Диагностика половых инфекций может осуществляться по анализу крови, например, на ПЦР 4 ИППП. Как подготовиться к кровосдаче на такое обследование? Правила в данном случае едины как для мужчин, так и для женщин, и ничем не отличаются от забора крови, скажем, на сахар или биохимию. Сдаётся анализ с утра, обязательно на голодный желудок.
Если на исследование берется биоматериал из влагалища или уретры, нужно сохранять половой покой в течение двух суток, а за пару – тройку часов до взятия материала лучше не ходить в туалет «по-маленькому». Так в вагине и/или уретре накопится наибольшее число бактерий, и анализ мазка даст достоверный результат о наличии возбудителей заболеваний. И, конечно, не стоит мыть половые органы антибактериальным мылом или каким-то антисептическим средством, по крайней мере, в день сдачи анализа.
Недопустимо проходить исследование на инфекции во время приёма антибиотиков. Лучше сдавать анализ на заразные заболевания половой сферы, выждав месяц после окончания курса лечения. Иначе возможно искажение результата исследования.
Как сдать анализ на ИППП женщине
Анализ крови на ИППП как для мужчин, так и для женщин проводится одинаково. А вот как сдать анализ на ИППП женщине, если необходимо исследование влагалищного мазка? Этот биоматериал берется доктором-гинекологом в ходе обычного осмотра на кресле. Однако, у пациенток возникает много вопросов относительно данного анализа: на какой день цикла женщинам нужно приходить, чтобы у нее взяли мазок, и можно ли сдавать во время месячных анализ?
Мазок на ПЦР 4 ИППП (на четыре основные половые инфекции, в число которых входят хламидиоз, гонорея, уреаплазмоз, трихомониаз) не сдается при наличии менструальных выделений. Брать у женщин влагалищные выделения на исследования необходимо в период с седьмого по девятый день менструального цикла, через пару дней после того, как заканчивается кровотечение.
За неделю до взятия комплексного анализа на вагинальные инфекции нужно закончить приём местных противозачаточных средств, а за два-три дня – вагинальных свечей и влагалищных таблеток, которые назначали против гинекологических заболеваний.
Как сдать мужчине
Перечень инфекций, на которые необходимо обследоваться пациенту определяет врач исходя из симптомов, наблюдающихся у больного. Стандартный анализ – экспертиза на возбудители четырёх самых распространённых заболеваний. Если есть основания подозревать наличие определенного диагноза (например, если наблюдаются какие-то конкретные клинические признаки), то назначается исследование на эту инфекцию.
Анализ на ИППП у мужчин сдаётся также с предварительной подготовкой. Как уже было отмечено в предыдущих блоках, анализ крови на ИППП сдают мужчины с утра и на голодный желудок.
Анализ на инфекции, передающиеся половым путем проводится и с помощью других биоматериалов. Например, берется соскоб из передней части уретры или из мочеиспускательного канала, сок простаты или моча. И здесь нужна более тщательная подготовка к сдаче.
Если осуществляется проверка мочи, необходима утренняя порция, которая берется после сна. В холодильник биоматериал ставить нельзя, нужно сразу же после забора нести его в лабораторию.
Сдача мазка из уретры или мочевого канала происходит в кабинете у доктора. Перед этим мужчины должны воздерживаться от полового контакта в течение двух суток и пару-тройку часов потерпеть и не мочиться.
Как берут на ИППП сок простаты? Это делает также доктор. Он осуществляет массаж простаты через задний проход, в результате этого через мочеиспускательный канал выделяется секрет простаты, который собирается в пробирку. Стоит отметить, что эта процедура безболезненная, хоть и неприятная.
Перечень анализов на ЗППП
Получить ИППП вопреки распространённому мнению можно даже при наличии постоянного партнёра. Однако, многие люди стесняются обращаться к врачу лично. Для таких пациентов существует возможность сдать анализы на ЗППП анонимно без оглашения информации родственникам, знакомым и пр. Кроме этого, необязательно сообщать о себе всё врачу, достаточно пройти необходимые обследования и при необходимости указать на жалобы. Анонимное обследование проводится без огласки, а узнать результаты можно даже без личного визита в клинику, достаточно ввести код на сайте. На какие ЗППП нужно проверяться:
- Бактериальные половые инфекции. Основным возбудителем являются болезнетворные микроорганизмы, в перечень подобных заболеваний входят хламидиоз, сифилис, уреаплазмоз и пр.
- Вирусные заболевания. К самым распространённым относится ВПЧ, который может очень долгое время быть «невидимкой» и проявляться только на фоне сильно ослабленного иммунитета. Несмотря на существование относительно безопасных форм этого заболевания, некоторые случаи смертельно опасны. К другим вирусам относят гепатиты, герпес и ВИЧ.
- Паразитарные болезни. К ним относится педикулёз по причине заражения лобковыми вшами и чесотка.
В список обязательных анализов для мужчин входят следующие:
Анализ крови и мочи на ЗППП
К сдаче анализов на половые инфекции относят исследования крови и мочи. Анализ крови на ЗППП позволяет обнаружить антитела, которые вырабатывает организм для борьбы с инфекцией. К минусам этого метода относится невозможность определить тип возбудителя, можно обнаружить лишь его наличие. У мужчин кровь берут при прохождении медкомиссии в военкомате, женщинам же сдавать кровь на половые инфекции чаще всего приходится при планировании беременности.
Анализ мочи на ЗППП помогает обнаружить ряд болезней — кандидоз, гонорею, хламидиоз. Выявление возбудителя через мочу обусловлено тем, что при проходе через уретру она частично смывает лейкоциты и болезнетворные микроорганизмы. По состоянию мочи и её составу можно выявить наличие воспалительных процессов и состояние здоровья мочевыводящей системы.
Мазок на ЗППП
Мазок самый простой тест на ЗППП. Во время процедуры врач берёт небольшое количество материала из влагалища или шейки матки у женщин и из уретры у мужчин. Проверка на ЗППП позволяет обнаружить:
- трихомониаз;
- кандидоз;
- микоплазмоз;
- уреаплазмоз;
- гонорею и пр.
Мазки на ЗППП рекомендуется сдавать в следующих случаях:
- При наличии беспокоящих симптомов (зуд, выделения, боль и пр.).
- В качестве профилактики.
- Перед планированием беременности.
Комплексное обследование
В комплексный анализ на ЗППП входят обследования методом ПЦР. Достаточно одной процедуры, чтобы выявить от 10 до 20 венерических заболеваний. Для комплексного обследования берут соскоб клеток эпителия, при необходимости исследование дополняют анализом крови. Комплекс анализов сдают не только для точной диагностики заболевания, но и для проверки хода терапии. Сделать общий анализ на ЗППП можно в специализированной лаборатории или клинике.
Сделать общий анализ на ЗППП можно в специализированной лаборатории или клинике.
Иммуноферментный анализ
Заболевания, передающиеся половым путём, можно выявить с помощью ИФА. Этот метод заключается в обнаружении и исследовании антител. На разные типы возбудителей организм реагирует синтезом разных антител, что и позволяет поставить диагноз. Иммуноферментный анализ ЗППП позволяет выявить не только саму болезнь, но и срок развития инфекции.
Экспресс-тесты на ЗППП
Экспресс-тесты на ЗППП — отличный способ для тех, кто боится огласки, достаточно приобрести препарат в аптеке. По принципу действия такие средства схожи с тестами на беременность — по реакции полоски можно определить наличие болезни. Аптечные тесты на венерологические заболевания совершенно безопасны и продаются без рецепта.
Провериться на инфекции ЗППП в домашних условиях можно, но стоит учитывать несколько факторов:
- Экспресс-тестирование может быть неточным, если взятого материала недостаточно.
- Возможны ошибки при несоблюдении инструкции к средству.
- Тест не проявит полоски при наличии болезни, если срок годности истёк.
- Домашний тест может оказаться отрицательным даже при наличии заражения, если организм ещё не успел выработать антитела.
Чтобы не исказить результаты анализа, нельзя допускать попадания на полоску посторонних жидкостей. При положительном результате полоски приобретают другой цвет, который нужно сверить с приложенной таблицей. Если экспресс-тест показал наличие инфицирования половыми заболеваниями, необходимо срочно обратиться к врачу.
Какой метод диагностики выбрать?
Клиники предлагают готовые пакеты услуг: ПЦР на разное количество инфекций — от 3 до 16. На самом деле метод полимеразной цепной реакции действительно незаменим только при определении четырех возбудителей половых инфекций, это:
- ВПЧ (HPV16, 18, 31, 33, 35, 39, 45 и др.)— вирус папилломы человека;
- ВПГ (HSV 1, 2) — вирус простого герпеса;
- хламидия;
- микоплазма.
Из этого списка ПЦР на ВПЧ назначают только тогда, когда у женщины есть изменения на шейке матки. Просто так этот анализ не делают. ПЦР на герпес при отсутствии проявлений инфекции не имеет никакого смысла.
Остается анализ ПЦР на микоплазму и хламидию — это мелкие бактерии, выявить их другими методами можно, но гораздо сложнее. Хламидии вызывают всевозможные воспаления в мочеполовой системе. Хроническая инфекция может осложняться образованием спаек в малом тазу, а значит болями и, возможно, бесплодием. Считается, что даже бессимптомный хламидиоз опасен, хотя достоверных данных и прогнозов на этот счет нет. По , если хламидию нашли, это нужно лечить.
Чтобы выявить микоплазменную инфекцию, сдают количественный ПЦР, чтобы определить, сколько именно бактерий поселилось внутри. Большая часть микоплазм может существовать мирно, не причиняя вреда человеку, только если их больше 104 КОЕ/мл и есть признаки воспаления, назначают лечение.
Для других инфекций, передающихся половым путем, существуют не менее достоверные, но более дешевые и простые анализы:
- на сифилис — микроскопия мазка, иммуноферментный анализ (ИФА) крови;
- на гонорею, трихомониаз, кандидоз — микроскопия мазка, бактериологический анализ;
- на ВИЧ, гепатиты В, С — ИФА и ПИФ — иммунологические исследования крови.
ИППП у женщин

Список инфекций, передающихся половым путем.
Трихомониаз
При инфицировании этим заболеванием инкубационный период составляет от 1 до 3 недель. Течение трихомониаза подтверждает, что не всегда гнойные выделения из влагалища являются признаком наличия инфекции. Чаще всего при таком недуге женщина отмечает белые или желтовато-зеленые выделения пенистой консистенции, сопровождающиеся резким специфическим запахом. При их выделении секреция соприкасается со слизистой половых путей, чем вызывает интенсивное раздражение гениталий, сильный зуд и боль.
Очень важно выявить подобные нарушения на начальной стадии, так как трихомониаз имеет серьезные осложнения, которые влекут за собой воспаление мочеточников, уретры, яичников, фаллопиевых труб, а также поражение внутреннего слоя и шейки матки
Хламидиоз
Первые признаки хламидиоза у женщин отмечаются спустя несколько недель с момента инфицирования. Появляются гнойные выделения, неприятные ощущения в паху и нижней части живота, поясничном отделе спины, мочеиспускание становится болезненным. У женщин нередко возникают кровотечения между менструациями. Перечисленные симптомы нельзя игнорировать, поскольку возникновение данной патологии может спровоцировать воспаление шейки матки.
Хламидиоз негативно влияет на течении беременности, создает трудности в процессе родов. У новорожденного, мать которого инфицирована данным недугом, может развиться воспаление носоглотки, легких и конъюнктивит.
Микоплазмоз
Это заболевание развивается довольно стремительно, его первые симптомы у женщин обнаруживаются спустя три дня после инфицирования. В редких случаях выявление микоплазмоза происходит только спустя месяц. У женщин возникают мучительные боли при мочеиспускании, дискомфорт и зуд в области гениталий, при этом выделения из урогенитального тракта прозрачные и незначительные.
Во время течения этого заболевания у женщин не страдает функциональная деятельность репродуктивных органов. Основные проблемы со здоровьем связаны с хроническим воспалением половых органов.
Гонорея

Данная инфекция достаточно распространенная. У женщин она протекает с характерными для нее симптомами: уже через 1-2 недели после заражения появляются желто-зеленые выделения из влагалища, имеющие неприятный специфический гнойный запах.
Если длительное время игнорировать гонорею, страдает печень и селезенка, поскольку ослабевает иммунная система человека. Нередко гонорею у женщин выявляют только в случае, когда обращаются к врачу-гинекологу с жалобами на предположительный эндометрит, цистит или аднексит. Гонорея, как заболевание, способна вовлекать в патологический очаг ткани яичников, матки, фаллопиевых труб и анального отверстия. Самое опасное осложнение данного недуга – бесплодие.
Сифилис
Данное венерическое заболевание возникает в случае проникновения в организм возбудителя «бледной спирохеты». Его признаки у женщин заметны лишь спустя 3-4 недели с момента заражения. Выявить эту инфекцию достаточно просто: симптомы сводятся к появлению розеол, твердого шанкра и увеличению лимфатических узлов.
Твердый шанкр – это новообразование, указывающее на наличие сифилиса. Воспалительный элемент, как правило, заживает самостоятельно, ускорить процесс поможет лишь своевременно начатое эффективное лечение. Если увеличенные лимфоузлы находятся вблизи твердого шанкра – они безболезненны.
В числе остальных проявлений данной инфекции привлекает внимание чрезмерное выпадение волос. Если пациентка длительное время не обращается к врачу, происходит поражение внутренних органов, которое в 25% случаев приводит к необратимым последствиям
ИППП — что это такое?
Это условное сокращение, является комплексом заболеваний или инфекций, основной путь передачи которых — незащищенный сексуальный контакт.
Данные типы инфекций представляют собой патологии бактериальной, вирусной, грибковой этиологии.
Основной путь заражения — сексуальный контакт без использования средств контрацепции.
Также можно встретить термин «венерическая болезнь».
В данную группу принято относить ВПЧ-инфекцию, сифилис, гонококк, трихомоноз, герпес генитальный.
Другие разновидности ИППП предполагают не только половой путь передачи:
- трансплацентарный (хламидия)
- артифициальное заражение (ВИЧ, гепатит типы B и C)
- контактный (лобковые вши)
Иногда могут появляться симптомы, которые очень похожи на признаки ИППП, даже если у вас никогда не было секса.
В случае женщин, грибковая инфекция может быть спутана с венерической болезнью.
Мужчин могут беспокоить наличие образований на половом члене, которые в конечном итоге оказываются прыщами или раздраженными волосяными фолликулами.
По этим причинам важно проконсультироваться с врачом, если имеются сомнения относительно вашего сексуального здоровья







































